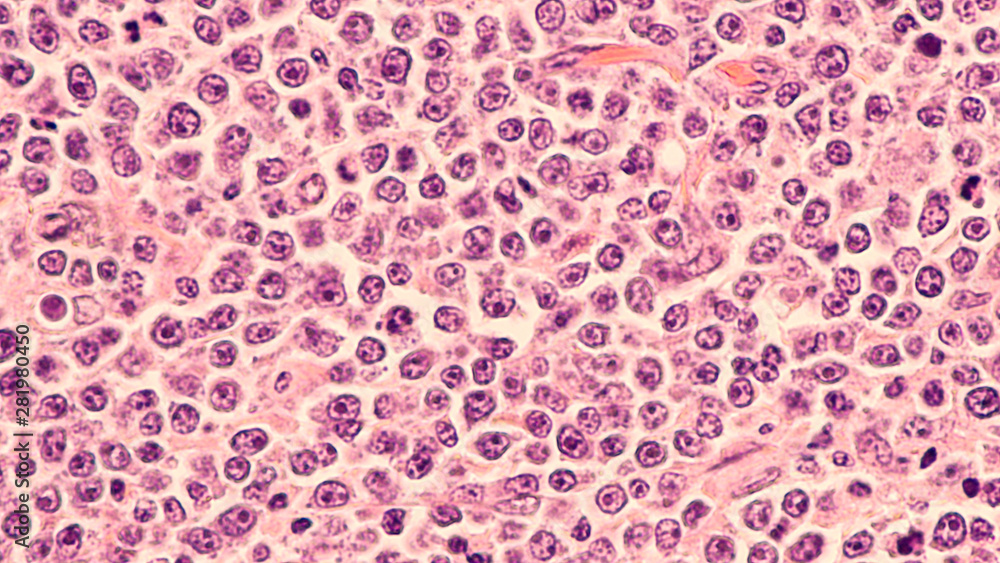

-
Marques & Merch
- Affiches de films
- Batman
- Spider-Man
- Star Wars
- Harry Potter
- MARVEL
- DISNEY
- Pokémon
- Tout voir
- Musique
- Queen
- Rolling Stones
- AC/DC
- Les Beatles
- Bob Marley
- Iron Maiden
- Metallica
- Tout voir
- Anime & Manga
- L'Attaque des Titans
- Pokémon
- Demon Slayer
- Jujutsu Kaisen
- Death Note
- Dragon Ball Z
- My Hero Academia
- Tout voir
- Comics
- Batman
- Spider-Man
- Superman
- Captain America
- Les Vengeurs
- MARVEL
- Wonder Woman
- Tout voir
- Affiches de jeux vidéo
- Assassin's Creed
- Nintendo
- Playstation
- Jeux en ligne
- Xbox
- Minecraft
- Sonic
- Tout voir
- Posters pour enfant
- Harry Potter
- Rick et Morty
- Lilo & Stitch
- DISNEY
- La Reine des neiges
- Mickey Mouse
- Princesses
- Tout voir
-
Illustration
- Par catégorie
- Illustrations abstraites
- Collections noir & blanc
- Affiches de voyage
- Citations et textes
- Touche de nature
- Collages
- Line Art
- Man Cave
- Mode
- Motifs pour enfants
- Romantique
- Illustrations sportives
- Magazine Cover
- Women Power
- Animaux
- Une inspiration quotidienne pour votre maison ou votre bureau
- Par style
- Bauhaus
- Naturel
- Rétro & vintage
- Inspiration asiatique
- Scandinave
- Art déco
- Bohème
- Elégance parisienne
- Tropical
- Pop art
- Provence
- Harmonie & calme
- Romantique
- Industriel
-
Tableaux
- Tableaux sur toile
- Tableaux sur toile
- Toiles multi-panneaux
- Tableaux sur toile -60 %%
- Tout voir
- Tableaux
- Affiches encadrées -20 %%
- Toile personnalisée avec photo
- Encadrement: Cadres et accroches
- Reproductions de tableaux
- Toiles multi-panneaux
- Reproductions de tableaux
- Florent Bodart
- Paul Cézanne
- Claude Monet
- Pierre-Auguste Renoir
- Sam Toft
- Leonardo da Vinci
- Alfons Mucha
- Hieronymus Bosch
- Gustave Klimt
- Wassily Kandinsky
- Leonetto Cappiello
- Vincent van Gogh
- Katsushika Hokusai
- Tout voir
-
Photos
- Par catégorie
- L'élégance du noir & blanc
- Animaux
- Nature & Paysage
- Voyage autour du monde
- Preuve d'amour
- Moments de la vie quotidienne
- Macro
- Aventure exotique
- Beauté minimaliste
- Old school
- Affiches panoramiques
- Mondes délicieux
- Dans les montagnes
- Vue aérienne
- Photos artistiques
- Nature fragile
- Le pays des merveilles hivernales
- Des détails surprenants
- La beauté de l'architecture
- Les coins du bord de mer
- L'élégance du mouvement
- Esthétique sportive
- La magie de la différence
- Monde Magique
- Nuit urbaine
- Un voile de mystère
- Niveau d'apaisement
- L'art autour de nous
-
Affiches et Posters
- Encadrement: Cadres et accroches
- Cadres en stock
- Réglettes pour poster
- Accessoires
- Décorations murales
- Plaques en métal
- Jeu de posters
- Posters / Papiers peints de porte
- Autocollants pour meubles
- Posters XXL
- Affiches panoramiques
- Affiches encadrées -20 %%
- Marques & Merch
- Affiches de films
- Musique
- Anime & Manga
- Comics
- Affiches de jeux vidéo
- Posters pour enfant
- Sports
- Célébrités
- Affiches et Posters
- Populaires - TOP
- Nouveautés
- Imprimez vos photos
- Marques & Merch
- Dernière chance -60 %%
- Réductions jusqu'à -80 %%
- Décorations murales
- Encadrement: Cadres et accroches
- Motifs
- Affiches drôles
- Affiches éducatives - École
- Affiches érotiques
- Animaux
- Architecture
- Art abstrait
- Auto - Moto - Aérien
- Cartes
- Célébrités
- Drapeaux
- Encouragement et Citations
- Fantaisie
- Fêtes, Célébrations, Vacances
- Histoire et religion
- Illustration
- L’univers
- Mode
- Nature & Paysage
- Noir & Blanc - Black & White
- Nourriture & boissons
- Pour votre entreprise
- Reproductions de tableaux
- Romantique
- Sports
- Villes & pays
- Voyage
-
Papiers peints
- Papiers peints -60 %%
- Populaires
- Autocollants
- Choix du designer
- Papiers peints de films
- Superhéros
- Animé
- Séries TV
- Fantaisie
- Papiers peints par motifs
- Auto - Moto - Aérien
- L’univers
- 3D papiers peints
- Architecture
- Thèmes de jeux
- Papiers peints de musique
- Planisphères
- Motifs pour enfants
- Nature & Paysage
- Papiers peints d'art
- Motifs & Ornements
- Animaux
-
-20 %Calendriers 2026
- Calendrier de l'Avent
- Calendriers - Auto, Moto
- Calendriers - Films et séries
- Calendriers - Animaux
- Calendriers - Artistes
- Calendriers - Erotiques
- Calendriers - Jeux vidéo
- Calendriers - Musique
- Calendriers - Personnalités
- Calendriers - Retro & Vintage
- Calendriers - Spirituel
- Calendriers - Sport
- Calendriers - Villes
- Calendriers - Voyage
- Calendriers 3D
- Calendrier de l'Avent
- Calendriers - Auto, Moto
- Calendriers - Films et séries
- Calendriers - Animaux
- Calendriers - Artistes
- Calendriers - Erotiques
- Calendriers - Jeux vidéo
- Calendriers - Musique
- Calendriers - Personnalités
- Calendriers - Retro & Vintage
- Calendriers - Spirituel
- Calendriers - Sport
- Calendriers - Villes
- Calendriers - Voyage
- Calendriers 3D
- Tout voir
-
Tasses & vaisselle
- Vaisselle
- Cannettes & boîtes à déjeuner
- Bouteilles
- Décapsuleur
- Dessous de verre
- Verres
- Verres à liqueur
- Assiettes & Bols
- Vaisselle par motif
- Anime vaisselle
- Vaisselle Auto-moto
- Vaisselle rétro
- Vaisselle d’artistes célèbres
- Fantaisie vaisselle
- Films et séries
- Photos
- Jeux vidéo
- Vaisselle pour enfant
- Musique
- Comics
- Vaisselle sport
- Humour vaisselle
- Nouveaux produits
-
Vêtements
- Vêtements
- Sweats à capuche & Pulls
- Casquettes & Bonnets
- Vêtements d'hiver
- Chaussettes et collants
- Pantalons
- Pyjamas et vêtements de nuit
- Peignoirs et serviettes
- Sacs
- Portefeuilles
- Bijoux & accessoires beauté
- Parapluie
- Manchons de gaming
- Sous-vêtements
- Nouveaux produits
- T-shirts & Tops
- T-shirts pour femmes
- T-shirts pour hommes
- T-shirts pour enfant
- T-shirts – Notre collection
- T-shirt photo personnalisé
- T-shirts -60 %%
- T-shirts par marque
- T-shirts de musique
- T-shirts d'anime
- T-shirts de films & TV
- T-shirts de jeux vidéo
- Harry Potter
- Star Wars
- Le Seigneur des Anneaux
- MARVEL
- Batman
- T-shirts par thème
- T-shirts d’artistes célèbres
- T-shirts à motifs sportifs
- T-shirts abstraits
- T-shirts aux motifs asiatiques
- T-shirts Line Art
- T-shirts nourriture & boissons
- T-shirts avec des animaux
- T-shirts Auto Moto
- T-shirts à motifs enfantins
- T-shirts avec des drapeaux
- T-shirts amusants
- T-shirts avec citations
- T-shirts Bauhaus
- T-shirts Pop Art
- Soutien à l’Ukraine
-
T-shirts & Tops
- Sweats à capuche & Pulls
-
Casquettes & Bonnets
-
Vêtements d'hiver
- Chaussettes et collants
- Pantalons
- Pyjamas et vêtements de nuit
- Peignoirs et serviettes
-
Sacs
-
Portefeuilles
-
Bijoux & accessoires beauté
- Parapluie
- Manchons de gaming
-
Vêtements par imprimés
-
Vêtements pour :
- Sous-vêtements
- Nouveaux produits
- Tout voir
-
 T-shirts – Notre collection
T-shirts – Notre collection
 T-shirts pour femmes
T-shirts pour femmes
 T-shirts pour hommes
T-shirts pour hommes
 T-shirts de musique
T-shirts de musique
 T-shirts de films & TV
T-shirts de films & TV
 T-shirts de jeux vidéo
T-shirts de jeux vidéo
-
Cadeaux & Jeux
- Cadeaux & Jeux
- Cadeaux photo
- Chèque Cadeau
- Jouets
- Cadeaux idéaux pour
- Noël
- Cadeaux pour hommes
- Cadeaux pour femmes
- Cadeaux pour enfants
- Cadeaux pour couple
- Cadeaux pour collectionneurs
- Cadeaux pour étudiants
- Cadeaux pour animaux
- Merch
- Accessoires d’intérieur
- Plaques en métal
- Sets cadeaux
- Petits cadeaux à prix doux
- Figurines
- Répliques de collection
- Jouets
- Tasses & vaisselle
- Calendriers 2026 -20 %%
- Fournitures scolaires & de bureau
- Cadeaux rétro en métal
- Puzzles
- Sacs
- Carnets
- Fournitures d'art
- Affiches encadrées -20 %%
- Jouets
- Poupées
- MGA's Miniverse
- LEGO
- Peluches
- Figurines d'action et jouets
- Voitures miniatures
- CarTuned
- Hot Wheels
- Cartes à jouer
- NERF
- Jeux de société
- Cubes illustrés
-
Pour votre entreprise
- Pour votre entreprise
- Beauté et bien-être
- Studio de mariage
- Hôtellerie
- Médecins
- Affiches éducatives - École
- Studio de remise en forme
- Héros des rues
- Bureau
- Experts et hommes d'affaires
- B2B Partners
- Beauté et bien-être
- Studio cosmétique
- Studio de tatouage
- Barbier
- Bien-être & Spa
- Salon de coiffure
- Studio d'ongles
- Studio de remise en forme
- Gym & Fitness
- Esthétique sportive
- Illustrations sportives
- Automobilist
- Yoga
- Dance
- Football
- Cadres & Encadrement
- Cadeaux photo
L'affiche ne contient ni filigrane ni #numéro de catalogue.
Les couleurs de l'impression peuvent légèrement différer de celles qui apparaissent sur votre écran.
Tableau sur toile Lymphoma awareness: photomicrograph of a diffuse large B-cell lymphoma (DLBCL) a type of non-Hodgkin lymphoma de David A Litman
 4.7 3 816 avis
4.7 3 816 avis
Choisir des options d'impression supplémentaires
Plus d'alternatives pour la fixation murale
Description du produit
Tableau sur toile
L'image sur toile crée un effet 3D unique sur le mur. La toile est tendue sur un cadre en bois de haute qualité. Traitement idéal pour les photographies, reproductions et autres graphiques artistiques. La dernière technologie en impression haute résolution. Décoration élégante pour la chambre à coucher, le bureau ou le salon.La toile est soigneusement tendue sur un cadre en bois robuste, disponible en deux profondeurs : 2 cm pour un aspect plus délicat ou 4 cm pour un effet plus prononcé. Des matériaux de haute qualité et un savoir-faire précis garantissent une longue durabilité. Une impression sur toile est un excellent choix et une décoration élégante pour tout intérieur.
Avis et évaluations des clients

4.7 / 5
(3 816 avis)
Avis affichés pour: Photos
Participez au concours de photos instagram et gagnez un bon d'achat de 40 € !


1. Téléchargez une photo de vos produits achetés sur votre Instagram.
2. Marquez notre profil :
@europostersfr_merch.
3. Gagnez !
Nous tirons au sort des gagnants chaque mois. Croisons les doigts !
Produits similaires
Contact
FAQ
A propos de nous
Paiement et livraison
Conditions génerales de vente
Politique de retour
Politique de confidentialité
Promotions et réductions
Programme de fidélité
Vos remarques
Cadres & Encadrement
Autocollants
Collaborations
Pour les artistes
Pour les influenceurs
Pour les groupes et autres marques
Pour les partenaires B2B
Europosters – Décorez votre vie
Depuis 1999, Europosters est l'un des premiers vendeurs de posters, impressions murales et produits dérivés officiels en République Tchèque et partout en Europe. Dans notre offre, vous trouverez une grande sélection de posters de films, de jeux, de sports dans toutes les tailles, aussi bien qu'un large choix de cadeaux originaux pour les fans de Star Wars, Harry Potter, comics, Warner Bros. Nous avons que les tasses, figurines, puzzles ou vêtements sont des cadeaux appréciés à tous les âges. Mais si vous êtes fan de décoration d'intérieur, vous êtes au bon endroit aussi! Nous imprimons du papier peint, des illustrations, des photos et des toiles tous les jours pour les expédier dans 25 pays différents, et rendre nos clients heureux.
Contact:
E-mail: info@europosters.eu
Téléphone: +44 20 3996 3131 (en anglais)
Lundi – Vendredi ǀ 7:00–17:00
© 1999–2025 Europosters. Tous droits réservés.
Nous récompensons les clients fidèles!
En vous inscrivant, vous acceptez notre politique de confidentialité..

Sélectionné
Sélectionné


















